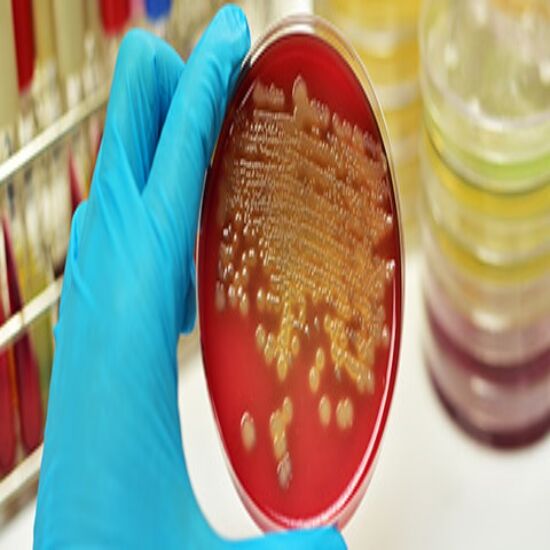

Book Stool Culture and Sensitivity Appointment Online Near me at the best price in Delhi/NCR from Ganesh Diagnostic. NABL & NABH Accredited Diagnostic centre and Pathology lab in Delhi offering a wide range of Radiology & Pathology tests. Get Free Ambulance & Free Home Sample collection. 24X7 Hour Open. Call Now at 011-47-444-444 to Book your Stool Culture and Sensitivity at 50% Discount.
The cultured stool test detects infectious bacteria in the digestive tract and diagnoses stomach issues. This test distinguishes between healthy and infectious gut flora. If you have stomach pain, diarrhea, blood in stool, nausea, and fever, it is advised.
Infectious microorganisms enter the body through contaminated food and water or drug side effects that destroy good microbes and promote the growth of infectious bacteria.
Immediately treatable following diagnosis. If neglected, significant fluid loss may necessitate hospitalization.
The stool culture test is performed as follows:
The lab technician will provide details.
No care is required.
The Stool Culture and Sensitivity Test cost varies INR 500 to INR 2800 by region and facility. So constantly get tested at trustworthy diagnostic centers like Ganesh Diagnostic. It is staffed by trained and experienced professionals to assure patient and visitor safety.
| Test Type | Stool Culture and Sensitivity |
| Includes | Stool Sample Culture Test (Gastroenterology) |
| Preparation | |
| Reporting | Within 24 hours* |
| Test Price |
₹ 700
|

A stool culture is generally done to find cause of the different symptoms. It will also help in explaining the symptoms such as severe or the bloody diarrhea or if there is increased amount of gas. It can also help find the cause of nausea, vomiting, loss of appetite, bloating, belly pain and cramping, and fever.
A stool culture is generally done to find cause of the different symptoms. It will also help in explaining the symptoms such as severe or the bloody diarrhea or if there is increased amount of gas. It can also help find the cause of nausea, vomiting, loss of appetite, bloating, belly pain and cramping, and fever.
The stool test helps in examining the sample of feces in the designated laboratory. There are also different types of the stool tests, which would be required for checking for the following:
Most of the people with your gastroenteritis do not need any of the tests, but sometimes the doctor would also refer you for a stool culture.
The Stool culture was seen to have a sensitivity of 33.3% (7/21) and about 97.4% (38/39) specific for the detection and presence of V cholera, when the PCR was considered as your gold standard.
The Doctors could order the bacteria stool culture and look for an illness-causing bacteria such as:
You would have to secure your lid on the container(s), and then you could place them in a resealable bag. Bring stool specimen to the Laboratory Service Center as soon as it is possible. If one cannot bring it right away, some of the specimens may need to be then refrigerated or even frozen.
There are usually no risks associated with the fecal culture test. However, if the stool sample might contain infectious pathogens that you can could spread to the others. Be also sure to wash the hands thoroughly with an antibacterial soap after collecting your sample.
The Stool that comes in range of the colors. All the shades of brown and even the green are considered normal. Only the rarely does your stool color indicates a potentially serious intestinal condition. The Stool color is also generally influenced by what amount of the bile, yellow-green fluid that also digests fats in the stool.
Normal stool color is brown. This is also due to presence of the bile in stool. The Normal stool color that could range from light yellow to brown to almost black. If stool is also red, maroon, black, clay-colored, pale, yellow, or even green this could signify a problem.
Early check ups are always better than delayed ones. Safety, precaution & care is depicted from the several health checkups. Here, we present simple & comprehensive health packages for any kind of testing to ensure the early prescribed treatment to safeguard your health.